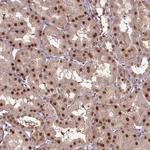
CEP83 Antibody in Immunohistochemistry (Paraffin) (IHC (P))

Search
Invitrogen
CEP83 Polyclonal Antibody
{{$productOrderCtrl.translations['antibody.pdp.commerceCard.promotion.promotions']}}
{{$productOrderCtrl.translations['antibody.pdp.commerceCard.promotion.viewpromo']}}
{{$productOrderCtrl.translations['antibody.pdp.commerceCard.promotion.promocode']}}: {{promo.promoCode}} {{promo.promoTitle}} {{promo.promoDescription}}. {{$productOrderCtrl.translations['antibody.pdp.commerceCard.promotion.learnmore']}}

Please note: We are reviewing Western blot images included in the antibody testing data in our catalog, including those provided by third parties. Unless expressly labeled or annotated as “raw-unedited”, Western blot images included in the antibody testing data in our catalog may have been edited, optimized or otherwise adjusted for presentation.
产品信息
PA5-146808
种属反应
宿主/亚型
分类
类型
抗原
偶联物
形式
浓度
规格
纯化类型
保存液
内含物
保存条件
运输条件
RRID
产品详细信息
Immunogen sequence: LKRLQEKVEV LEAKKEELET ENQVLNRQNV PFEDYTRLQK RLKDIQRRHN EFRSLILVPN MPPTASINPV SFQSSAMVPS MELPFPPHMQ EEQHQRELSL
Highest antigen sequence identity to the following orthologs: Mouse - 89%, Rat - 90%.
靶标信息
Component of the distal appendage region of the centriole involved in the initiation of primary cilium assembly. May collaborate with IFT20 in the trafficking of ciliary membrane proteins from the Golgi complex to the cilium during the initiation of primary cilium assembly.
仅用于科研。不用于诊断过程。未经明确授权不得转售。
篇参考文献 (0)
生物信息学
蛋白别名: Centrosomal protein of 83 kDa; Cep83; Coiled-coil domain-containing protein 41; Renal carcinoma antigen NY-REN-58
基因别名: CCDC41; CEP83
Entrez Gene ID: (Human) 51134



